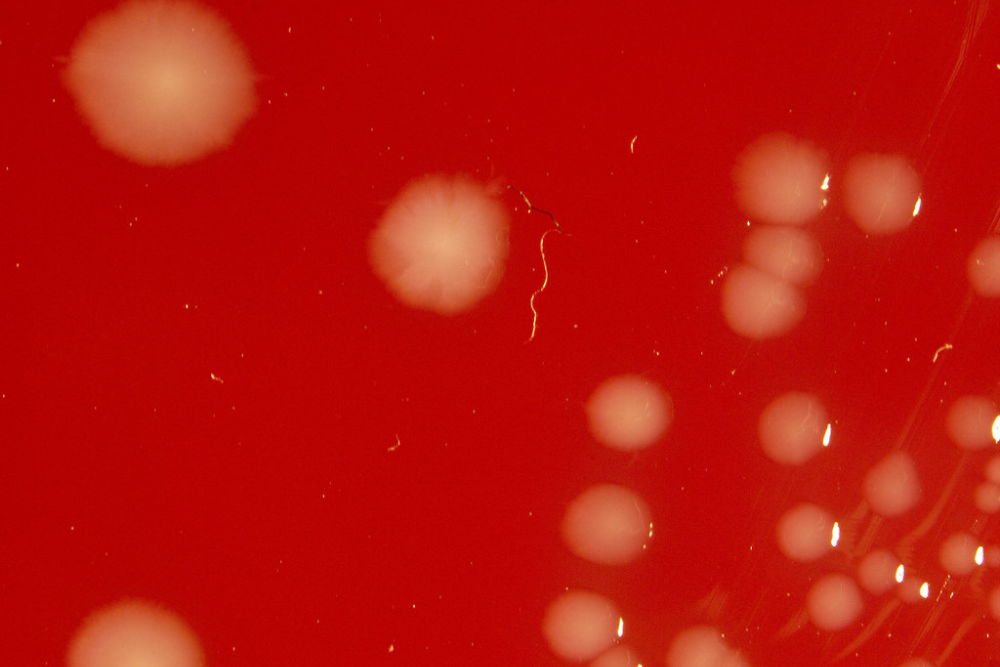

14 Creatures Capable of Living Without Oxygen
One basic principle governs most life on Earth: oxygen is necessary for survival. The metabolic processes that keep all living things alive, including humans, the majority of animals, plants, and even numerous bacteria, depend on oxygen.
However, some amazing organisms have discovered ways to survive without this seemingly essential gas since nature loves exceptions. The world beneath our feet and in extreme environments houses fascinating organisms that defy our conventional understanding of life.
Here are 14 creatures that can survive without oxygen, demonstrating just how adaptable life can be.
Loricifera

These microscopic marine animals were discovered in the Mediterranean Sea’s L’Atalante Basin, an oxygen-free zone that has been that way for thousands of years. Loricifera are the first known multicellular animals that can complete their entire life cycle without oxygen.
Instead of mitochondria like most creatures, they use hydrogenosomes—organelles that produce energy in oxygen-free environments.
Spinoloricus

Another member of the Loricifera phylum, Spinoloricus has evolved to thrive in the harsh, oxygen-depleted conditions of deep-sea hypersaline basins. These tiny creatures measure less than a millimeter and have specialized cellular machinery that functions without oxygen.
Their metabolism relies on hydrogen and sulfates rather than oxygen, making them true marvels of evolutionary adaptation.
Like Go2Tutors’s content? Follow us on MSN.
Henneguya salminicola

This parasitic cnidarian made headlines in 2020 when researchers discovered it had completely lost its mitochondrial genome, meaning it cannot breathe oxygen. It infects salmon tissue and has evolved to survive by absorbing nutrients directly from its host.
This creature represents one of evolution’s most extreme adaptations, essentially abandoning the cellular equipment that almost all other animals require.
Methanogenic Archaea

These ancient microorganisms thrive in oxygen-free environments like deep underground rocks and animal digestive tracts. They produce methane as a byproduct of their metabolism, earning them the nickname ‘methane makers.’
Many methanogenic archaea are so sensitive to oxygen that exposure can actually kill them – the complete opposite of most life forms.
Desulfovibrio vulgaris

These bacteria can survive in oxygen-free conditions, such as deep ocean sediments, because they have mastered the art of sulfate reduction. They use sulfate as the last electron acceptor in their respiratory pathway rather than oxygen.
Because of their adaption, they can flourish in environments like oil fields and the human mouth where most other species would suffocate.
Like Go2Tutors’s content? Follow us on MSN.
Clostridium botulinum

The bacteria responsible for producing the deadliest toxin known to science actually require an oxygen-free environment to survive. When exposed to oxygen, they form protective spores, only becoming active again when conditions become oxygen-depleted.
It’s like having a built-in dormancy switch that activates only when the environment becomes hospitable.
Bacteroides fragilis
This common gut bacteria helps with digestion and makes up about 30% of the bacteria found in the human intestinal tract. It’s strictly anaerobic, meaning it not only lives without oxygen but is actively harmed by it.
These microorganisms play crucial roles in our digestive health while existing in an environment that would be impossible for oxygen-dependent organisms.
Pyrococcus furiosus

Thriving in hydrothermal vents, this hyperthermophilic archaeon lives in extremely hot, oxygen-free environments. Its name means ‘rushing fireball,’ appropriate for an organism that grows optimally at temperatures around 212°F (100°C).
Instead of using oxygen, it performs a fermentation process using sulfur compounds, producing hydrogen sulfide as waste – the compound responsible for the smell of rotten eggs.
Like Go2Tutors’s content? Follow us on MSN.
Naegleria fowleri

Known as the ‘brain-eating amoeba,’ this single-celled organism can switch between aerobic and anaerobic metabolism depending on environmental conditions. When oxygen is absent, it can alter its biochemical pathways to survive.
This metabolic flexibility allows it to thrive in diverse environments, from warm freshwater to the human nervous system.
Giardia intestinalis

This intestinal parasite lacks mitochondria and instead has mitosomes—simplified organelles that don’t use oxygen for energy production. Giardia causes giardiasis, a diarrheal disease, and has evolved to live in the intestinal tract’s low-oxygen environment.
Its simplified cellular structure represents a unique evolutionary path away from oxygen dependence.
Entamoeba histolytica

Another intestinal parasite, this amoeba causes amoebiasis and has adapted to live in the oxygen-poor environment of the human large intestine. It contains organelles called mitosomes that function without oxygen, allowing it to thrive where most eukaryotic cells would fail.
This adaptation makes it particularly difficult to eliminate from the body.
Like Go2Tutors’s content? Follow us on MSN.
Trichomonas vaginalis

This parasite causes the most common non-viral sexually transmitted infection worldwide and has hydrogenosomes instead of mitochondria. These specialized organelles produce molecular hydrogen as a metabolic byproduct rather than using oxygen.
The organism’s ability to function without oxygen allows it to colonize the relatively oxygen-poor reproductive tract.
Fasciola hepatica

The common liver fluke has adapted to live in environments with fluctuating oxygen levels, including the oxygen-poor bile ducts of its mammalian hosts. It possesses both aerobic and anaerobic metabolic pathways, allowing it to switch between them as needed.
This metabolic flexibility is like having an emergency backup generator that kicks in when the main power fails.
Ascaris lumbricoides

The giant intestinal roundworm can switch between aerobic and anaerobic metabolism depending on its life stage and environment. In the oxygen-poor intestine, it relies on fermentation pathways to generate energy.
These worms can grow up to 14 inches long within the human intestine, representing one of the largest organisms capable of anaerobic metabolism.
Like Go2Tutors’s content? Follow us on MSN.
Life’s Remarkable Adaptability

The existence of these oxygen-free organisms challenges our fundamental understanding of what makes life possible. From deep-sea sediments to the human gut, these creatures have carved out niches in environments that would be lethal to most life forms.
Their unique metabolic pathways not only help scientists understand the flexibility of life but also provide clues about how life might exist on other planets where oxygen is scarce or absent. These anaerobic organisms also remind us that life on Earth didn’t always depend on oxygen – for billions of years before plants evolved and flooded our atmosphere with oxygen, anaerobic life forms dominated the planet.
In a very real sense, these oxygen-free creatures are living fossils, offering a glimpse into Earth’s ancient past when the air we breathe would have been toxic to most organisms alive today.
More from Go2Tutors!

- 18 Unexpectedly Valuable Collectibles You Might Have Lying Around
- 15 Things Every Teenager in the ’70s Did That Teens Today Wouldn’t Understand
- 15 Strange Things People Have Tried to Ban (And Failed)
- 15 Inventions That Were Immediately Banned After Being Created
- 20 Actors Who Were Almost Cast in Iconic Roles
Like Go2Tutors’s content? Follow us on MSN.